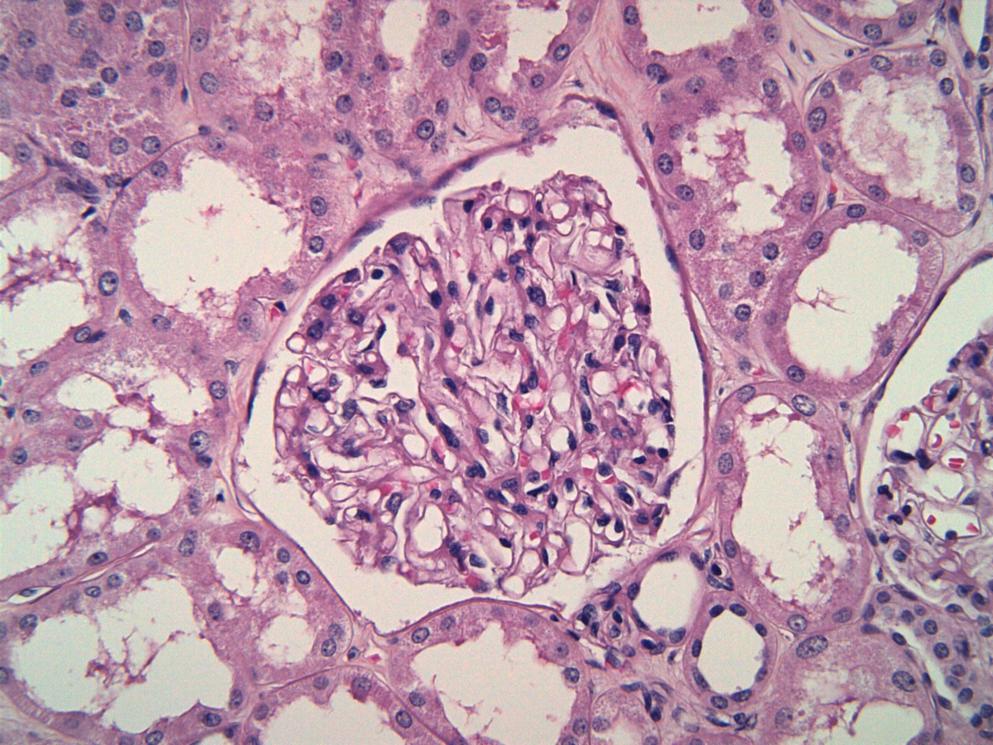

Welcome
Complement-mediated kidney diseases (CMKDs) are chronic and progressive diseases in which dysregulation of the complement cascade causes or plays a key role in their pathophysiology1-3. CMKDs include C3 glomerulopathy (C3G), atypical hemolytic uremic syndrome (aHUS) 3,4, IgA nephropathy (IgAN), membranous nephropathy (MN) and immune-complex membranoproliferative glomerulonephritis (IC-MPGN)2-5.
CMKDs can have a devastating impact on patients, and progression to kidney failure is associated with an increased risk of mortality2-4,6-8.
There are many unmet needs in the management of CMKDs, particularly for improved diagnosis and more effective treatment options9-11. As we learn more about the complex pathophysiology of each disease, more investigational treatments that target key drivers or mediators of CMKDs are progressing through clinical development4,10,12.
Complement inhibition is a key strategy showing promise for treatment of various CMKDs2,4,11. So far, two complement inhibitors have been approved by the US Food and Drug Administration (FDA) and the European Medicines Agency (EMA) treatment of aHUS (eculizumab and ravulizumab), and numerous others are being investigated in clinical trials across other types of CMKDs4,12-17.
The growing number of complement inhibitors in clinical development may help to address unmet needs for more effective treatment strategies for CMKDs, with potential to improve outcomes for patients with these devastating diseases4,10,11
In our CMKDs Learning Zone, explore the types of CMKDs, their pathophysiology, impact and unmet needs, as well as recent advances in the diagnosis and treatment. Listen to expert opinion on gaps in management and learn about investigational treatments in the clinical development pipeline. Dive into recent developments in CMKDs through our congress highlights, including the latest insights from the World Congress of Nephrology 2023. Explore data from the latest clinical trials and research on CMKDs in our publication digest series.
Complement in kidney disease
Explore types of CMKDs and key unmet needs
C3 glomerulopathy
Learn about the burden of C3G, diagnosis and emerging treatments
IgA nephropathy
Delve into the impact and pathophysiology of IgAN
Expert opinion
Learn about clinical trial progress and real-world evidence in CMKDs
Publication digests
Summaries of key research and clinical trial findings
Why learn about CMKDs?
An improved understanding of which rare kidney diseases can be considered as complement-mediated and considerations for diagnosis of each condition may assist healthcare professionals in recognising the signs and symptoms of these diseases. It may also assist with differential diagnosis in practice.
More details on key pathways involved in the development and progression of CMKDs, existing treatment options and investigational treatments in clinical development will assist healthcare professionals in understanding how emerging treatment options may help to address unmet needs for patients with CMKDs.
More educational content coming soon to the CMKDs Learning Zone
Interested in learning more about CMKDs, and treatments currently in clinical development? More educational content is coming soon to the CMKDs Learning Zone.
Bookmark this page to stay informed with upcoming content for CMKDs Learning Zone via the button at the bottom of this page. We will notify you when new content becomes available on Medthority.
About the CMKDs Learning Zone
The aim of this Learning Zone is to improve understanding of the role of complement in kidney disease and encourage earlier and optimal management of CMKDs.
They key objectives of the CMKDs Learning Zone are:
- Recognise the role of complement in the pathophysiology of C3G
- Recall the role of complement in the pathophysiology of IgAN
- Identify the requirements to confirm a diagnosis of C3G
- Select the requirements to confirm a diagnosis of IgAN
- Identify which investigational complement inhibitors are in clinical trials for C3G and/or IgAN
- Select appropriate treatment strategies for management of C3G, based on 2021 KDIGO glomerular disease management guidelines
- Identify appropriate treatment strategies for management of IgAN, based on 2021 KDIGO glomerular disease management guidelines
This Learning Zone is intended for nephrologists, urologists, specialists and general practitioners.
Meet the experts
The following experts provided insights on CMKDs and/or reviewed the CMKDs Learning Zone.
Dr Carla Nester
Dr Carla Nester is the Jean Robillard Professor of Pediatric Nephrology and the Division Director of Pediatric Nephrology, Dialysis and Transplantation at the Stead Family Children’s Hospital, University of Iowa. Dr Nester leads a translational research program focusing on the rare CMKDs. She is also the primary investigator for the C3 Glomerulopathy Natural History Study, the largest cohort of rare C3G patients in North America. She is an advisor to KidNeeds, a global C3G family community. Dr Nester is also involved in clinical trials, and her clinical practice has become a hub for bringing the new generation of anti-complement therapeutics to a rare disease population.
Disclosures: Dr Nester has been involved in advisory boards and acted as a site investigator for Novartis, BioCryst and Apellis. She has also been a site investigator for ChemoCentryx, Alexion Pharmaceuticals and Retrophin. Dr Nester has been on a Data Safety Monitoring Board for Kira. She has also received honoraria from UpToDate, and funding from the National Institutes of Health.
Dr Edwin Wong
Dr Edwin Wong is a consultant nephrologist at Newcastle upon Tyne Hospitals NHS Foundation Trust and associate clinical lecturer at Newcastle University. Dr Wong’s academic renal training took place in Newcastle where he completed his Medical Research Council funded Clinical Research Training Fellowship. His research surrounded the study of complement abnormalities in aHUS, C3G and membranoproliferative glomerulonephritis (MPGN), with his work being published in top-ranking nephrology journals (J Am Soc Nephol/ Kidney Int). Dr Wong was awarded a Doctoral Thesis Prize for his PhD in 2016 and the prestigious Renal Association (Young Investigator) Raine Award in 2017.
Dr Wong’s clinical time is currently divided between the National Renal Complement Therapeutics Centre and Renal Services. His main clinical role is providing expert advice for the diagnosis and management of atypical haemolytic uraemic syndrome (aHUS) and C3 glomerulopathy (C3G) nationally. This includes implementing the NHS England Highly Specialised Services policies on the use of eculizumab in the treatment of these conditions.
Dr. Wong has been the UK chief investigator for trials of iptacopan in C3 glomerulopathy and IgA nephropathy. He is currently an investigator for both APPEAR and APPLAUSE – phase 3 studies in C3G and IgAN respectively.
Disclosures: Dr Edwin Wong has consultancy agreements for Apellis, Biocryst, Novartis, Omeros and Q32 Bio. He also has speaker’s agreements for Novartis and Alexion.
Dr Christoph Licht
Dr Christoph Licht is a staff nephrologist and Medical Director of Dialysis and Apheresis Program in the Division of Nephrology at The Hospital for Sick Children (SickKids) in Toronto, Canada. He is also a senior scientist in the SickKids Research Institute Cell Biology Program, a professor at the University of Toronto in the Departments of Paediatrics, Institute of Medical Science and Laboratory Medicine and Pathobiology and Medicine; and Associate Staff Physician in Medicine at UHN Toronto General Hospital.
Dr Licht is an international expert on CMKDs. His work has advanced the understanding of the pathogenesis and management of aHUS and C3G, and he has authored over 145 peer-reviewed publications and multiple book chapters. Dr Licht’s laboratory has made significant contributions to knowledge of the consequences of complement activation on platelets, neutrophils and endothelial/epithelial cells, and has established a series of functional assays allowing for the assessment of patients with (suspected) complement-mediated diseases. In current research projects the Licht lab explores the role of complement in tissue homeostasis beyond the kidneys, and of intracellular complement.
Disclosures: Dr Licht has been a scientific advisor, data safety monitoring board member and/or speaker for Alexion Pharmaceuticals, Inc; Apellis Pharmaceuticals, Inc; Catalyst Biosciences; Eleva GmbH; Novartis and OPKO Health, Inc. He has also received unrestricted grants from Aurin Biotech, Fresenius and Pfizer, Inc.
Dr Andrew Bomback
Dr Andrew Bomback is Associate Professor of Medicine at Columbia University Irving Medical Center, where he is the Co-Director of the Center for Glomerular Diseases.
Disclosures: Dr Bomback has been a consultant/advisory board member for Achillion/Alexion, Apellis, Catalyst, Chemocentryx, Novartis, Silence, Visterra and Q32.
References
- Heiderscheit AK, Hauer JJ, Smith RJH. C3 glomerulopathy: Understanding an ultra-rare complement-mediated renal disease. Am J Med Genet C Semin Med Genet. 2022;190(3):344-357.
- Poppelaars F, Thurman JM. Complement-mediated kidney diseases. Mol Immunol. 2020;128:175-187.
- Willows J, Brown M, Sheerin NS. The role of complement in kidney disease. Clin Med (Lond). 2020;20(2):156-160.
- Fakhouri F, Schwotzer N, Golshayan D, Frémeaux-Bacchi V. The rational use of complement inhibitors in kidney diseases. Kidney Int Rep. 2022;7(6):1165-1178.
- So BYF, Chan GCW, Yap DYH, Chan TM. The role of the complement system in primary membranous nephropathy: A narrative review in the era of new therapeutic targets. Front Immunol. 2022;13:1009864.
- Wang X, Van Lookeren Campagne M, Katschke KJ, Jr., Gullipalli D, Miwa T, Ueda Y, et al. Prevention of fatal C3 glomerulopathy by recombinant complement receptor of the Ig superfamily. J Am Soc Nephrol. 2018;29(8):2053-2059.
- Glassock RJ. Mortality Risk in IgA Nephropathy. J Am Soc Nephrol. 2019;30(5):720-722.
- Kościelska-Kasprzak K, Bartoszek D, Myszka M, Żabińska M, Klinger M. The complement cascade and renal disease. Arch Immunol Ther Exp. 2014;62(1):47-57.
- Feldman D, Bomback A, Nester C. National Kidney Foundation. The voice of the patient - C3 glomerulopathy (C3G). 2018. Available at: https://www.kidney.org/sites/default/files/C3G_EL-PFDD_VoP-Report_3-29-18.pdf.
- Meuleman MS, Grunenwald A, Chauvet S. Complement C3-targeted therapy in C3 glomerulopathy, a prototype of complement-mediated kidney diseases. Semin Immunol. 2022:101634.
- Andrighetto S, Leventhal J, Zaza G, Cravedi P. Complement and Complement Targeting Therapies in Glomerular Diseases. Int J Mol Sci. 2019;20(24).
- National Institutes of Health US National Library of Medicine. Clinicaltrials.gov. https://clinicaltrials.gov/ct2/home. Accessed 12 January 2023.
- Ort M, Dingemanse J, van den Anker J, Kaufmann P. Treatment of rare inflammatory kidney diseases: Drugs targeting the terminal complement pathway. Front Immunol. 2020;11:599417.
- Eculizumab EPAR - Product Information. September 2022. Available at: https://www.ema.europa.eu/en/documents/product-information/soliris-epar-product-information_en.pdf. Accessed 31 January 2023.
- Eculizumab (Soliris) Full Prescribing Information (US FDA). November 2020. Available at: https://www.accessdata.fda.gov/drugsatfda_docs/label/2020/125166s434lbl.pdf. Accessed 31 January 2023.
- Ravulizumab EPAR - Product Information. April 2022. Available at: https://www.ema.europa.eu/en/documents/product-information/ultomiris-epar-product-information_en.pdf. Accessed 31 January 2023.
- Ultomiris (Ravulizumab-cwvz) - Full Prescribing Information (US FDA). July 2022. Available at: https://www.accessdata.fda.gov/drugsatfda_docs/label/2022/761108s021lbl.pdf. Accessed 31 January 2023.
- Kidney Disease: Improving Global Outcomes Diabetes Work Group. KDIGO 2021 Clinical Practice Guideline for the Management of Glomerular Diseases. Oct 2021.
This content has been developed independently by Medthority who previously received educational funding in order to help provide its healthcare professional members with access to the highest quality medical and scientific information, education and associated relevant content.